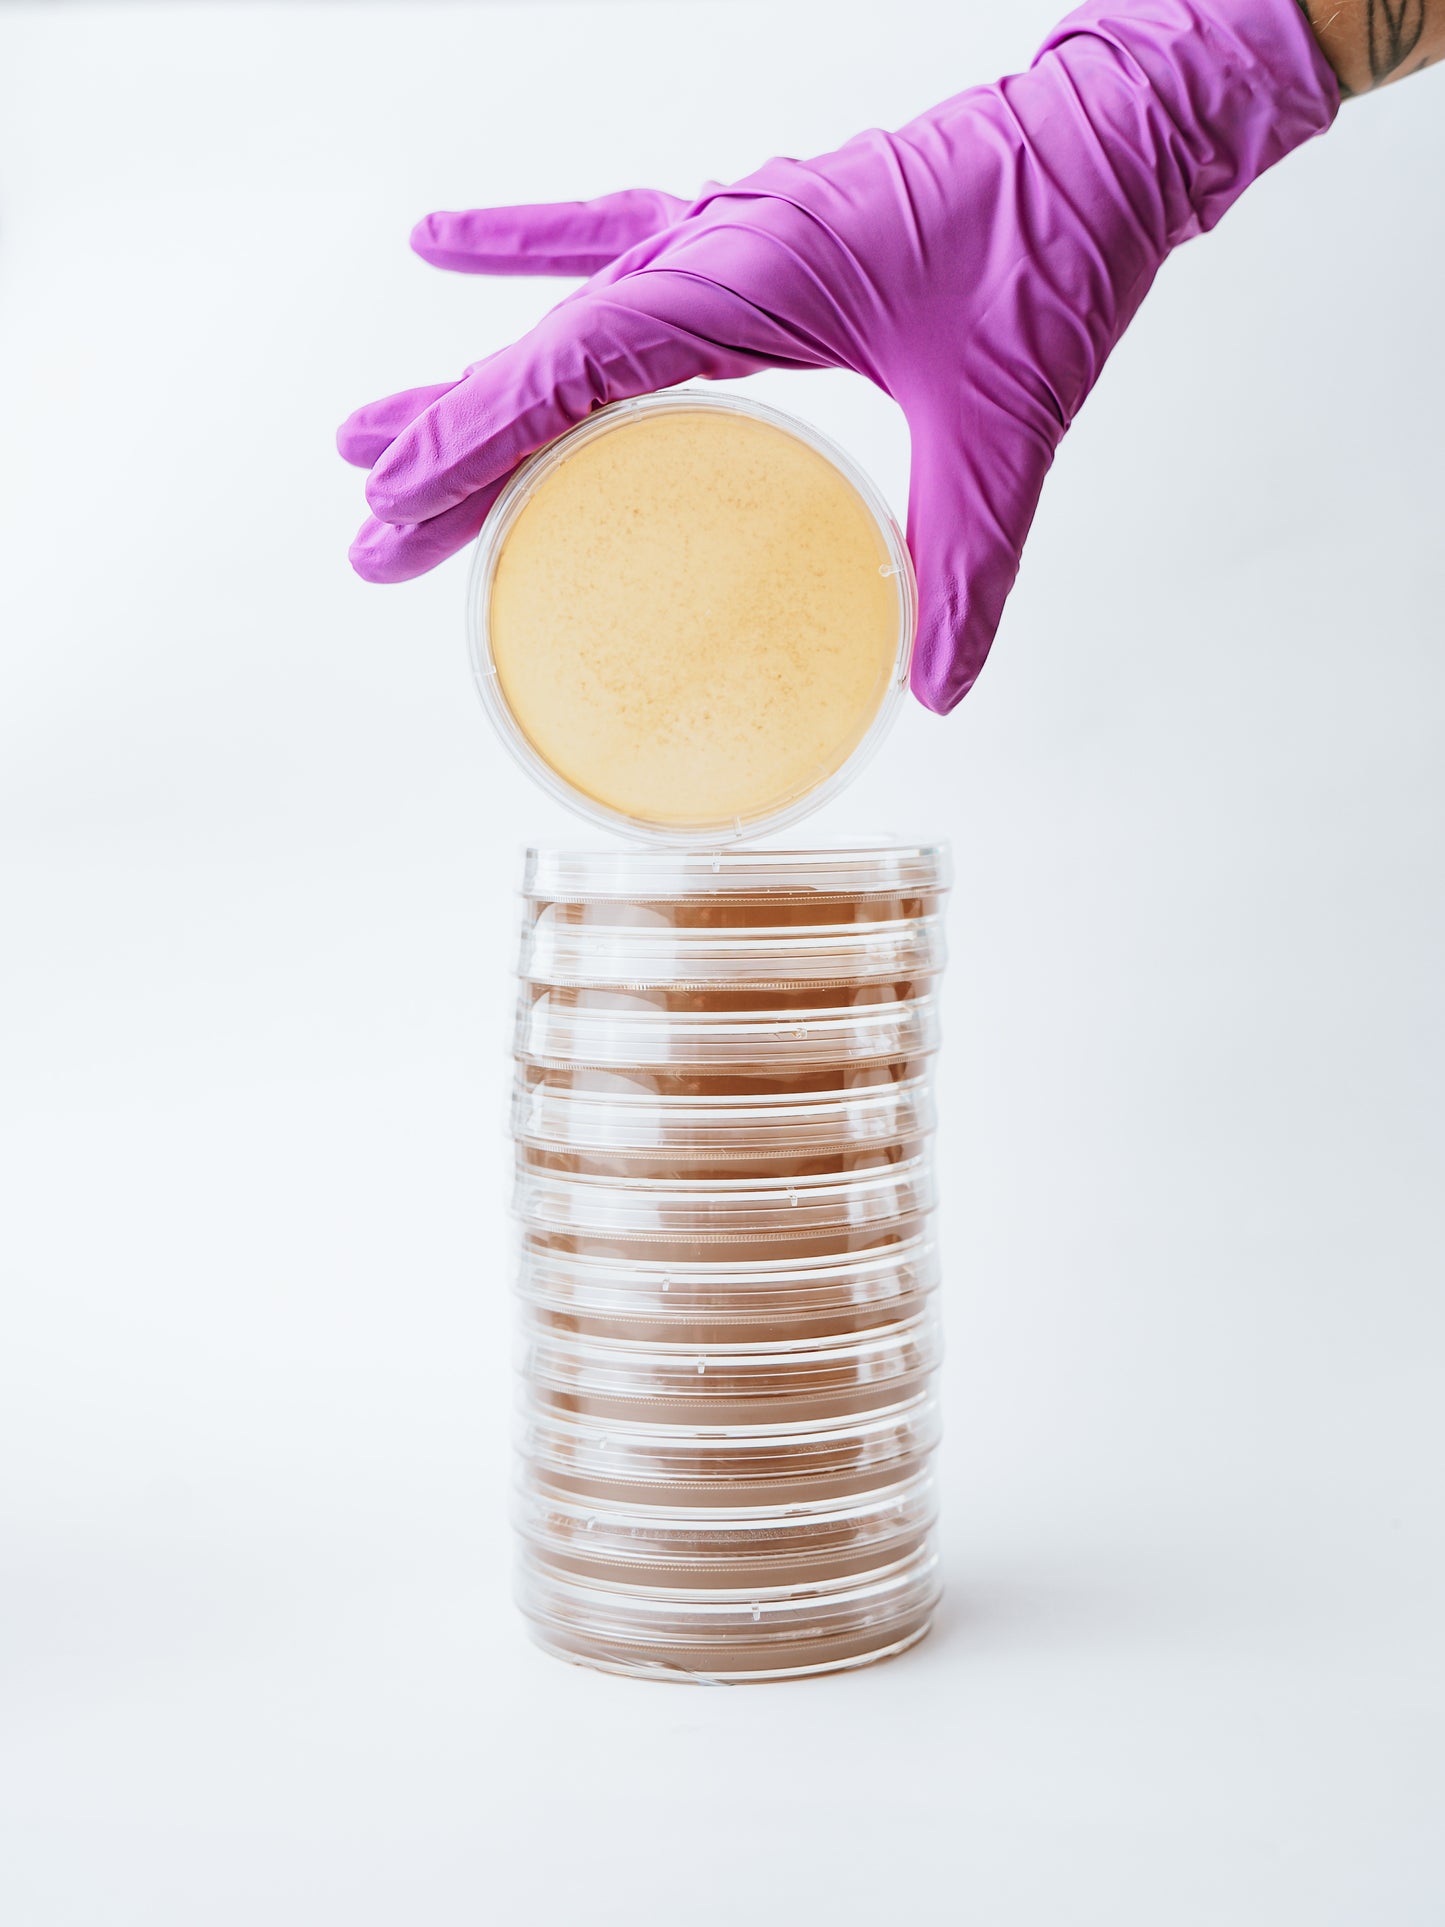
Stack Of Agar Plates From Spore Sorcery

Pre-Poured Agar Plates - 10pk/20pk
Pre-Poured Agar Plates - 10pk/20pk
Streamline your mycology work with our Pre-Poured Agar Plates, available in 10-pack and 20-pack options for your convenience. Each plate comes pre-poured with nutrient-rich Malt Extract Yeast Agar (MEYA), ensuring consistent quality and optimal nutrition for a variety of fungi and bacterial cultures. These sterile, ready-to-use plates save you time and offer a contamination-free environment, perfect for your culturing needs.
Couldn't load pickup availability
Ideal for use in sterile environments or gloveboxes, these plates support a range of applications, from strain isolation and direct inoculation with syringes to working with spore prints and cloning. Best results are achieved when used fresh; refrigerate until ready for use.
Whether you're a home cultivator or part of a larger operation, our pre-poured agar plates provide the reliability and convenience you need to cultivate with confidence.
Features:
-
Available in 10-pack or 20-pack options
-
Pre-poured with high-quality MEYA for balanced nutrition
-
Sterile and ready for immediate use
-
Suitable for various fungi and bacterial cultures
-
Consistent clarity and nutrient balance for robust growth
Eliminate the hassle of preparing agar and focus on what matters most – growing and experimenting. These plates are perfect for both beginners and seasoned mycologists!